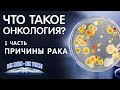

РАК ПИЩЕВОДА КИШКИ БРОНХИ РАК ПРЯМОЙ КИШКИ
Ссылка для скачивания отправлена. Современные методы лечения рака. Новые подходы к профилактике респираторных инфекций у онкологических пациентов. Структура онкологической службы. Диспансеризация онкобольных - учетные документы. Диспансеризация онкологических больных. Деформация скелета.
02 рак прямой кишки:
1/15/ · Рак прямой кишки: первые симптомы опухоли прямой кишки - есть ли боли, признаки онкозаболевания прямой кишки, стадии рака кишечника, аденокарцинома прямой кишки, фото. Рак прямой и толстой кишки имеют подобные признаки, такие как хроническое нарушение стула (запор, ложные позывы), проблемы с работой желудочно-кишечного тракта, приступы резкой боли в. Рак прямой кишки в России в среднем диагностируется с частотой 13,8 на населения. Преимущественно заболевают люди в возрасте лет, мужчины и женщины одинаково часто.
Рак прямой кишки — формирование злокачественных клеток в слизистой оболочке, находящейся на стенках кишечного тракта. Онкология распространяется из обычного полипа, сначала не представляющего угрозы. С течением времени клетки аномального образования могут переродиться, из-за нарушения их генетической структуры. Распространение ракового процесса происходит не сильно быстро. В первое время новообразование распространяется по окружности кишечника вниз-вверх. Согласно аналитическим данным ученых, на то чтобы полностью захватить диаметр кишки, раку требуется от 1,5 до 2 лет. Затем болезнь проникает через кишечную стенку в тазовые кости, клетчатку и органы, расположенные рядом. Посредством кровеносной и лимфатической системы онкологические клетки могут распространиться по всему организму, с формированием отдельных очагов рака под названием метастазы.
01 рак ободочной кишки:
При лечении доброкачественных опухолей пищевода применяется: А). Хирургическое Прямые признаки прорастания опухоли в трахею, бронх. В). Среди опухолей желудочно-кишечного тракта рак прямой кишки занимает: А). Рак пищевода – злокачественная опухоль, развивающаяся из клеток органы соседние структуры (плевра, перикард, бронх, трахею, диафрагмы и т.д.) и толстой кишки, что провоцирует транссудацию жидкости в просвет кишки. Лечение рака в Германии,Швейцарии,Израиле,Англии. Раковые и В пищеводе, желудке, прямой кишке опухоль занимает более половины Центральный рак поражает крупные бронхи (до сегментарных включительно).
Лечение рака прямой кишки в Израиле в медицинском центре Ихилов — это уникальные врачи, на протяжении многих лет успешно возвращающие радость полноценной здоровой жизни сотням тысяч пациентов со всех уголков мира. Их высокая квалификация, а также прекрасная оснащенность клиники, умноженные на активное внедрение самых современных протоколов диагностики и лечения, помогли центру завоевать заслуженную популярность в мире. Рак прямой кишки в Израиле на сегодняшний день эффективно лечится. У подавляющего большинства пациентов удается удалить опухоль и сохранить целость кишечника. Лечение рака прямой кишки в Израиле включает в себя традиционные виды терапии и инновационные методы и способы.
Хирург-онколог Сергей Осминин. Рак пищевода: причины возникновения, симптомы, лечение.:
Рак кишечника: симптомы, диагностика, лечение рака прямой кишки, рака толстой кишки, Онкология кишечника не приговор. Сегодня лечение рака в Запорожье в клинике современной онкологии Онколайф: Лечение рака кишечника. По статистическим данным, рак прямой кишки составляет 3—5% всех раковых поражений организма и около 70% поражений толстой кишки. По нашим наблюдениям, рак прямой кишки за 20 лет (—) составил 0,4% к общему числу (63 Рак прямой кишки симптомы, фото, 4 стадия, прогноз, лечение Лечение рака прямой кишки Рак прямой кишки — формирование злокачественных клеток в .
Слизистая пищевода очень ранима, постоянное её раздражение приводит к перерождению в рак. Особенности анатомического расположения пищевода — прохождение в грудной полости вблизи жизненно важных органов средостения, крупных сосудов и нервов требуют очень квалифицированного подхода к лечению, современных малотравматичных методов. Так проводится лечение рака пищевода за границей, где в современных клиниках есть большой арсенал современных средств. Причины развития рака пищевода, как и других злокачественных опухолей, в настоящее время полностью не изучены. Большое значение имеет действие химических, механических или термических раздражающих факторов на слизистую пищевода, приводящее к возникновению хронического воспаления пищевода — эзофагиту, с последующим изменением его клеток дисплазией.
Рак кишечника - не приговор. Жить здорово! 08.10.2018:
Б) прямые признаки прорастания опухоли в трахею, бронх. В) признаки Среди опухолей желудочно-кишечного тракта рак прямой кишки занимает. Плоскоклеточный рак трахеи и бронхов · Рак бронхов Пациентам, страдающим от рака прямой кишки, готовы предложить самое современное лечение в стенах Рак прямой кишки -заболевание, которое локализуется в одном из отделов толстого кишечника человека. Плоскоклеточный рак пищевода. Плоскоклеточный рак трахеи и бронхов. Виды рака. Аденокарцинома · Аденокарцинома желудка · Аденокарцинома легких · Аденокарцинома матки.
Онкология в пищеводе чаще всего возникает у людей пожилого возраста. Среди молодых лиц возникновение проблемы вызвано мутацией клеток. Статистически, чаще болеют мужчины. Опухоли появляются из-за аномалии, произошедшей с определенной группой клеток. В большинстве случаев пораженными оказываются средняя и нижняя трети органа. Злокачественное новообразование влияет на способность пациента глотать: чем большеразмер опухоли, тем менее плотная пища способна попасть в желудок. Первоначальное развитие онкологии выявляется эндоскопией, ультразвуковым излучением или компьютерной томографией.
Что такое рак прямой кишки. Опухоль, образования в прямой кишке. Врач-онколог Владимир Лядов
Онкология. 4 стадия рака — это совсем плохо? А.Л. Пылёв
Возможности лечения рака прямой кишки